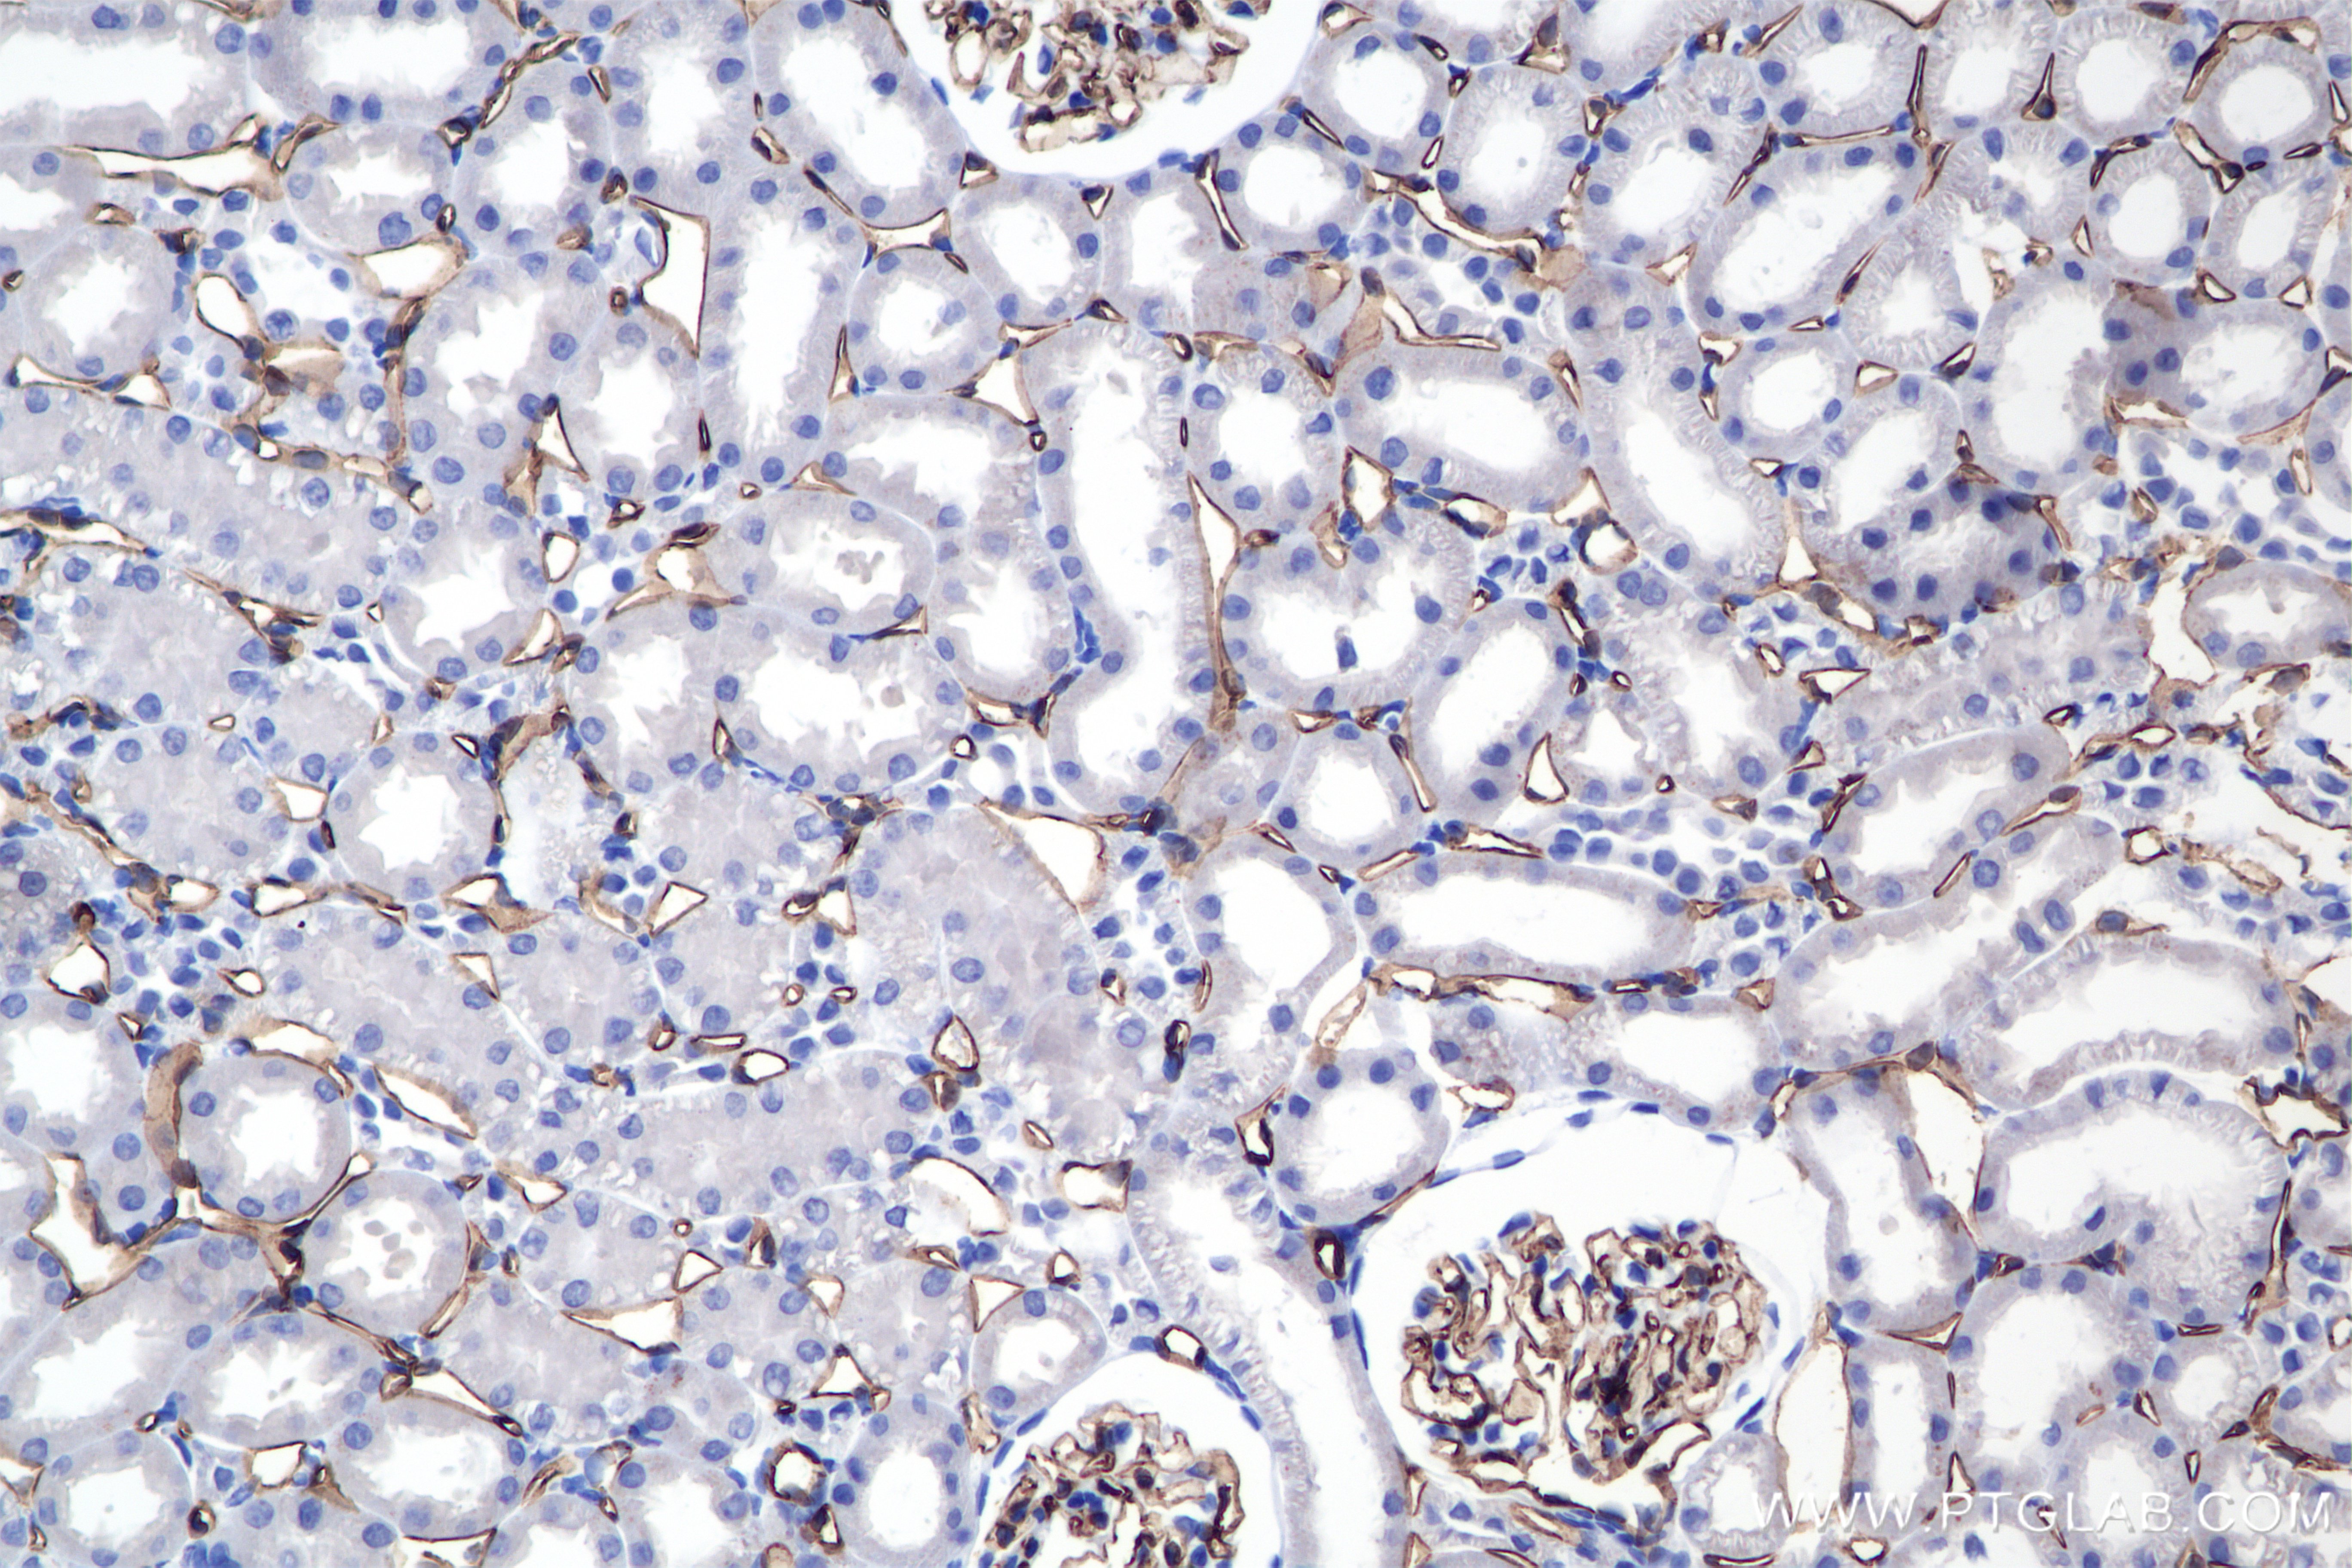

验证数据展示
经过测试的应用
| Positive WB detected in | mouse lung tissue, rat spleen tissue, rat lung tissue |
| Positive IHC detected in | rat liver tissue, rat kidney tissue Note: suggested antigen retrieval with TE buffer pH 9.0; (*) Alternatively, antigen retrieval may be performed with citrate buffer pH 6.0 |
| Positive IF-P detected in | rat liver tissue |
This antibody does not react with human CD31.
推荐稀释比
| 应用 | 推荐稀释比 |
|---|---|
| Western Blot (WB) | WB : 1:2000-1:10000 |
| Immunohistochemistry (IHC) | IHC : 1:500-1:2000 |
| Immunofluorescence (IF)-P | IF-P : 1:250-1:1000 |
| It is recommended that this reagent should be titrated in each testing system to obtain optimal results. | |
| Sample-dependent, Check data in validation data gallery. | |
发表文章中的应用
| IHC | See 1 publications below |
| IF | See 6 publications below |
产品信息
85898-4-RR targets CD31 in WB, IHC, IF-P, ELISA applications and shows reactivity with mouse, rat samples.
| 经测试应用 | WB, IHC, IF-P, ELISA Application Description |
| 文献引用应用 | IHC, IF |
| 经测试反应性 | mouse, rat |
| 文献引用反应性 | rat |
| 免疫原 |
CatNo: Eg1456 Product name: recombinant rat CD31/PECAM-1 protein Source: mammalian cells-derived, pHZ-KIsec-C-rFc Tag: C-rFc Domain: 18-589 aa of NP_113779.1 Sequence: QENSFTINSIHMESRPSWEVSNGQKLTLQCLVDISTTSKSRPQHQVLFYKDDALVYNVSSSEHTESFVIPQSRVFHAGKYKCTVILNSKEKTTIEYQLTVNGVPMPEVTVDKKEVTEGGIVTVNCSMQEEKPPIYFKIEKVELGTKNVKLSREKTSNMNFVLIEFPIEEQDHLLVFRCQAGVLSGIKMQTSEFIRSEYVTVQEFFSTPKFQIQPPEMIIEGNQLHIKCSVQVAHLAQEFPEIIIQKDKAIVATSKQSKEAVYSVMALVEHSGHYTCKVESNRISKASSILVNITELFPRPKLELSSSRLDQGEMLDLSCSVSGAPVANFTIQKEETVLSQYQNFSKIAEERDSGLYSCTAGIGKVVKRSNLVPVQVCEMLSKPRIFHDAKFEIIKGQIIGISCQSVNGTAPITYRLLRAKSNFQTVQKNSNDPVTFTDKPTRDMEYQCIVDNCHSHPEVRSEILRVKVIAPVDEVTISILSGNDVQSGDEMVLRCSVKEGTGPVTFQFYKEKEGRPFHEETVNDTQVFWHHEQTSKEQEGQYYCTAFNRASIVTSLRSGPLTVRVFLAPWKK 种属同源性预测 |
| 宿主/亚型 | Rabbit / IgG |
| 抗体类别 | Recombinant |
| 产品类型 | Antibody |
| 全称 | platelet/endothelial cell adhesion molecule 1 |
| 别名 | Pecam, Pecam1, PECAM-1, Platelet endothelial cell adhesion molecule |
| 计算分子量 | 76kDa |
| 观测分子量 | 100-130 kDa |
| GenBank蛋白编号 | NP_113779.1 |
| 基因名称 | Pecam1 |
| Gene ID (NCBI) | 29583 |
| RRID | AB_3744456 |
| 偶联类型 | Unconjugated |
| 形式 | Liquid |
| 纯化方式 | Protein A purification |
| UNIPROT ID | Q3SWT0 |
| 储存缓冲液 | PBS with 0.02% sodium azide and 50% glycerol, pH 7.3. |
| 储存条件 | Store at -20°C. Stable for one year after shipment. Aliquoting is unnecessary for -20oC storage. |
背景介绍
Platelet endothelial cell adhesion molecule-1 (PECAM-1, CD31) is a member of the immunoglobulin gene superfamily of cell adhesion molecules. CD31 is a transmembrane glycoprotein that is highly expressed on the surface of the endothelium, making up a large portion of its intracellular junctions. PECAM-1 is also present on the surface of hematopoietic cells and immune cells including platelets, monocytes, neutrophils, natural killer cells, megakaryocytes and some types of T-cell (PMID: 9011572). As well as its role in cell-cell adhesion, PECAM-1 functions as a signaling receptor, and is involved in important physiological events such as nitric oxide production, regulation of T-cell immunity and tolerance, leukocyte transendothelial migration and inflammation and angiogenesis (PMID: 21183735; 20978210; 17872453; 20634489).
实验方案
| Product Specific Protocols | |
|---|---|
| IF protocol for CD31 antibody 85898-4-RR | Download protocol |
| IHC protocol for CD31 antibody 85898-4-RR | Download protocol |
| WB protocol for CD31 antibody 85898-4-RR | Download protocol |
| Standard Protocols | |
|---|---|
| Click here to view our Standard Protocols |
发表文章
| Species | Application | Title |
|---|---|---|
Int J Biol Macromol Multifunctional double-network hydrogel with antibacterial and anti-inflammatory synergistic effects contributes to wound healing of bacterial infection. | ||
Int Immunopharmacol Punicalin ameliorates vascular endothelial cell pyroptosis and dysfunction induced by hyperlipidemia and hyperglycemia through activation of PPARγ. | ||
Zhonghua Shao Shang Yu Chuang Mian Xiu Fu Za Zhi [Effects of mitochondrial transplantation on full-thickness skin defects in diabetic rats]. | ||
Mater Today Bio 3D printing combined with thermally induced phase separation for engineering hierarchical osteogenic PLA scaffolds. | ||
J Nanobiotechnology Piezo-herbal microneedle patches enable wireless endometrial regeneration and fertility recovery. | ||
Acta Biomater Adhesive polyethylene glycol hydrogels with metformin enabling in-situ drug delivery reprogramming immuno-metabolism for tissue repair in diabetic foot ulcers. |